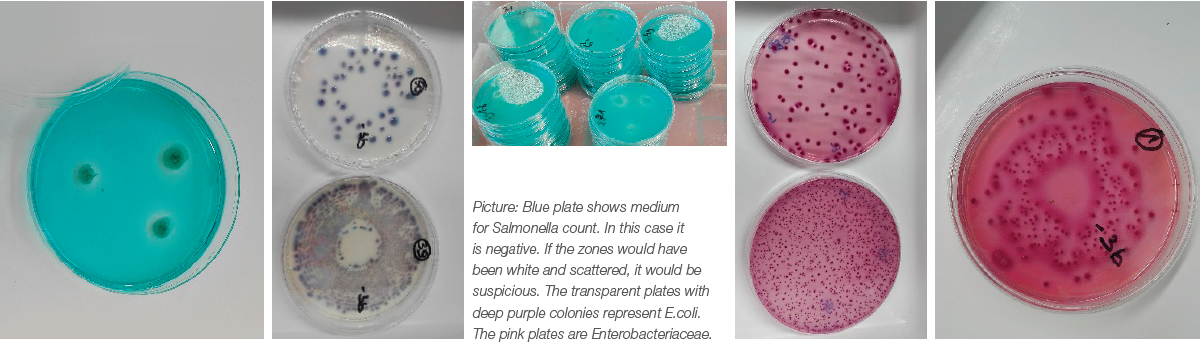

Coated calcium butyrate protects weaning pigs from diarrhea
Butyrate, a short chain fatty acid (C4), is produced by microbial fermentation in the large intestine of humans and animals. It serves not only as a primary nutrient that provides energy to colonocytes, but also as a cellular mediator regulating multiple functions of gut cells and beyond, including gene expression, cell differentiation, gut tissue development, immune modulation, oxidative stress reduction, and diarrhea control. Let's focus bit more on this last topic in this paper…
Butyric acid based products in general are used as a salt (sodium or calcium) or as glyceride because of the volatile and pungent nature of butyric acid. Butyrate is easily absorbed in the upper gastrointestinal tract when fed in the free salt form. To exert its antimicrobial and health effect, butyric acid salt needs to be in an undissociated state before reaching the hindgut, therefore the butyrate salt is encapsulated in a coating for protection. Conventional coated products found on the market however can be low in concentration of butyric acid, showing concentrations from 25 to 35% butyric acid, which is quite low. To increase this butyric acid concentration, Impextraco has developed a coating-process allowing to produce a well encapsulated product, BUTIFOUR® CCB, that contains 85% butyrate, allowing butyric acid levels of around 69%.
The current study evaluated the effect of BUTIFOUR® CCB on diarrhea incidence and composition of the microbiome. The study was conducted in a nursery barn with 120 weaned piglets, which were housed in 12 pens of 10 pigs each. Weaning age was 26 days and body weight at weaning averaged 7.1 kg. A primostarter diet was formulated and fed ad libitum from 1 week before weaning (in the sow barn) until 14 days post weaning to avoid additional stress due to changes of feed at weaning. Animals were dedicated to either 1 of the treatments. i.e. the control primostarter diet or the primostarter diet in which 1.5 kg/T BUTIFOUR® CCB was added. During the first 8 days post weaning, the faeces were given a score daily, according to the scoring system below.
Table 2. Percentage of pens within each treatment with a faecal score equal to 0, 1, 2 or 3, cumulative over the entire period. Faeces were scored daily during the first 8 days post weaning

1 out of 4 control pigs (27%) had a soft and shaped stool with no clinical signs of diarrhea. 1 out of 2 control animals (48%) had loose faeces and 1 out of 4 (25%) had watery faeces, indicating weaning diarrhea. With the addition of BUTIFOUR® CCB a reduction of 24% of high scored (score 3 or 4) animals was obtained, shifting these animals to a normal stool score of 2.
Microbial shedding in stool samples was determined after collection directly from rectum in sterile plastic bags. All E.coli counts above 105 were considered indicative for weaning diarrhea. Piglets fed the BUTIFOUR® CCB treatment had an average lower count for Enterobacteriaceae (CFU/g) and E.coli (CFU/g) compared to control, whereas Salmonella was absent for both treatments. These findings could be directly correlated to the better zootechnical performance and lower incidence of diarrhea in the BUTIFOUR® CCB treated animals.
The use of BUTIFOUR® CCB resulted in numerical better zootechnical results. Higher body weights at day 14 post weaning, higher average daily gain, higher feed intake and 14 point reduction in FCR during the first 14 days post weaning were recorded, see figures below.

Figure: Zootechnical performance at day 14 post weaning with and without BUTIFOUR® CCB supplementation.
In conclusion, BUTIFOUR® CCB protects your animals against weaning diarrhea to guarantee optimal performance. Interested to learn more about our BUTIFOUR® range or what else Impextraco can offer you? Visit us at Eurotier China.
For more of the article, please click here.
Article made possible through the contribution of Impextraco